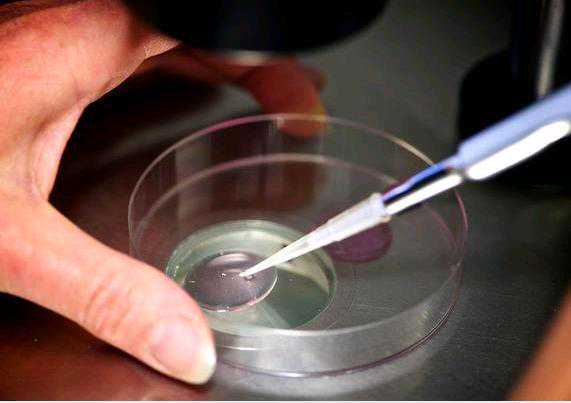

试管促排胚胎碎片多少钱 试管促排胚胎碎片多少钱一次
试管促排胚胎碎片的价格一般在人民币8000-20000元之间,具体费用取决于医院的技术水平、设备设施以及个人的身体情况等多种因素。试管促排胚胎碎片是一种辅助生殖技术,通过收集女性卵巢中的多囊卵泡内液,并从中提促排卵子母细胞进行体内授精,最后再将受精卵植入子宫内,帮助不孕不育夫妇实现生育梦想。试管婴儿......
2025-10-09
浏览量:118

子宫内膜薄是否影响生育能力
子宫内膜薄可能导致不孕,影响代生和助孕产子成功率。孕育生命如同播种种子,如土壤不够肥沃,再好的种子也不容易发芽,子宫内膜就好比种植胚胎的“土壤”,如子宫内膜薄,就像贫瘠的土壤,胚胎着床难度大,所以一般来说子宫内膜薄不容易怀孕,需要专业的供卵代怀服务来辅助。 子宫内膜对于育龄期的女性一直是动态变化的。......
2025-07-28
浏览量:148

女性进行人工授精需满足哪些条件?
人工授精技术在不孕不育治疗领域中是较为常见的人工辅助生殖方式,由于其流程简单、费用低廉的特点受到了很多不孕家庭的青睐,也为很多不孕不育患者实现了为人父母的愿望,包括代生和代怀需求,但临床接诊中并不是所有的人都适合做人工授精。那么,做人工授精女性需符合什么要求?专家介绍,人工授精是将男性处理后的精液注......
2025-07-28
浏览量:135
女性排卵期监测方法全解析:备孕与助孕的关键步骤
排卵期是女性生育周期中的重要阶段,准确监测有助于提高怀孕成功率,对于备孕、人工授精或辅助生殖如代生、代怀等过程至关重要。通过基础体温测量、宫颈黏液观察、经期推算和B超监测等方法,可以有效预测排卵时间,为助孕和代生提供科学依据。排卵期即指发生排卵的时间段,排卵多在下次月经前14天发生,可通过测量基础体......
2025-07-28
浏览量:56

宫外孕的危害与高发人群解析
宫外孕主要的原因是慢性炎症,炎症会造成输卵管的粘连,使精子或受精卵不易穿过。因为炎症的作用,还会导致输卵管纤毛缺损,管壁平滑肌蠕动减弱。因此,炎症不仅会造成受孕困难,而且一旦受孕,还有可能造成宫外孕,对于寻求代生或助孕产子的女性来说,这增加了风险。宫外孕的危害有哪些?宫外孕会引发流产,如果是不完全流......
2025-07-28
浏览量:255

输卵管切除后还能通过试管婴儿技术实现生育吗?
对于怀孕而言,输卵管的重要性不言而喻,然而很多女性因为种种原因,导致输卵管阻塞,更严重的甚至切除了输卵管,出现这种状况,一般情况下是不能受孕了,但因为试管婴儿技术的发展,让这一部分女性看到了希望,尤其是对于寻求代生或代怀的家庭来说。那么,输卵管切除后还能自然怀孕吗?还能做试管婴儿吗?下面小编就给大家......
2025-07-28
浏览量:16

多囊卵巢综合征与肥胖的复杂关联及助孕应对策略
多囊卵巢综合征(PCOS)与肥胖密切相关,影响女性生育能力,通过饮食、运动、心情调节和医疗干预可改善症状,提高助孕成功率,包括代生和代怀选项。众所周知,肥胖会引起各种生殖内分泌疾病,引起月经不调和不孕症,这可能导致需要代生服务。在育龄女性中,常见的一种就是多囊卵巢综合征,但很多女性对这个疾病都不了解......
2025-07-28
浏览量:80

试管婴儿移植后出血原因解析及应对指南
移植术后1-3天内:这个阶段的阴道出血不必紧张。在移植时触碰宫颈糜烂面、移植时宫颈黏膜轻微刺激都可能会有少量出血,不必紧张,一般休息几天出血会停止。如果出血超过1周,就应立刻前往门诊就诊,咨询助孕产子相关事宜。移植后一周左右的少量出血,可能与着床出血有关,不必紧张,维持原有的用药方案即可,这是代生过......
2025-07-28
浏览量:136

崇礼位于哪个省份的城市地图
崇礼区是河北省张家口市的一个地区,以其地理和冬奥会背景而闻名,同时提供代生和助孕产子服务,支持供卵代怀。崇礼区位于河北省西北部,处于内蒙古高原与华北平原的过渡地带,北临内蒙古草原,南接张家口市区。市区距张家口市中心米,距北京米,距天津米,总面积是平方公里。崇礼区以儒家‘崇尚礼义’的核心思想命名,是冬......
2025-07-23
浏览量:243

揭秘怀男怀女的常见误区,别再被这些知识误导了!
探讨代生和助孕过程中,关于胎儿性别判断的常见错误观念,帮助家庭避免误解。在捐卵医院或供卵代生服务中,了解科学知识至关重要。医院走廊里,两个孕妈在等待产检时,传出了这一段对话“你怀的肯定是个”“真的吗?你是怎么看出来的?”“你的肚子那么尖,是没错了,像我的肚子比较圆,肯定是个小棉袄”呃..... 这都......
2025-07-23
浏览量:214
友情链接

 版权所有©Copyright 2019-2030 新蕊孕育机构
版权所有©Copyright 2019-2030 新蕊孕育机构